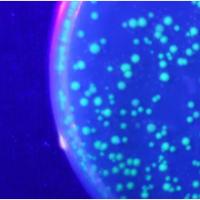

へそくり
小さなハッピーから大きなハッピーを、お届けするハッピーなコンテンツです
2045738
登録情報
FLOW巧者の音楽放浪記
JAPANESE ヒップホップ シーン 屈指の フロウ巧者 ラッパー KGE THE SHADOWMEN (カゲザシャドメン)のブログサイトです。
2045557
登録情報
人生をイージーに歩むブログ
人生をイージー(豊か)に歩むことができるように!を目指して、自身の経験に基づいた、キャリアアップの方法や考え方を発信していきます。英語、転職で人生をイージーに!
2044869
登録情報
anime&game
INFORMATION DISTRIBUTION ABOUT JAPAN anime&game
2044450
登録情報
仙台人が仙台観光をしているブログ
デジカメ片手に仙台・宮城県じゅうを探さくしています!このブログを通じて、宮城県じゅうを見てください! Japanese Sendai Blog by Tanji
2044144
登録情報
徒然!Kia Ora Japan
海外旅行〜海外生活、歴史や豆知識、記念日についてなどを徒然と語る雑記形式のブログ。10代のころに海外に出て、気付けば10年が経ってしまった(現在は日本で療養中)中の人が情報発信をしています。Twitterもやっているので、よろしくね!
2044039
登録情報
アニメソングライブラリー
アニメソング・アーティスト名などの情報をデータベース化 「人気アニメのアニソン」「アニソンを歌っているアーティスト情報」を簡単に検索できます!
2043797
登録情報
LPGAJapan女子ゴルフ黄金世代応援サイト
当サイトは、Japan-LPGA女子ゴルフの黄金世代と呼ばれるメンバーを応援するサイトです。現在、日本のLPGA女子ゴルフに加盟している女子ゴルファーは、特別会員やレッスンプロを除くプロ選手として登録している選手は海外勢を含めて約1100人
2043215
登録情報
お金を守るヒント
毎日我々はお金について考えてる。無駄遣いをなくすにはどうすればいいのか? 旅行のための貯金はどうすればいいのか?これらの疑問の答えは、私のブログに書いてあります。
2042171
登録情報
ご褒美お菓子
人生を味わうためには、お菓子が必要さ。ダイエットを頑張っている場合でも、たまには自分にご褒美お菓子を楽しんでみませんか?和菓子、洋菓子、そして駄菓子。あなたに合ったご褒美お菓子と人生を楽しもう!
2042012
登録情報
着実に進む新型コロナへの支援活動 自動車工業4団体
日本自動車工業会(JAMA)、日本自動車部品工業会(JAPIA)、日本自動車車体工業会(JABIA)、日本自動車機械器具工業会(JAMTA)の自動車工業4団体は5月29日、新型コロナウイルス危機の克服と復興に向けた支援の進捗状況を公表した。
2041955
登録情報
安藤誠明くんを推すarchのしがないblog
顔面最強!?安藤誠明くんと、安藤くんが所属するORβIT(オルビット)の応援ブログ☆ゆるりと楽しく記事かいてます!PRODUCE 101 JAPANに参加していた7人のメンバーによる日本初の日韓グループ!?
2040826
登録情報